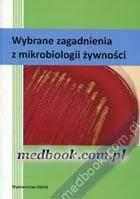
okładka

Autor
Błażejak, Stanisław Redakcja
Tytuł
Wybrane zagadnienia z mikrobiologii żywności
Miejsce wydania
Warszawa :
Wydawnictwo
Wydawnictwo SGGW,
Objętość
120 s., [11] s. tabl. :
Informacje dodatkowe
Bibliogr. przy rozdz. Bibliogr. przy rozdz.
Hasła przedmiotowe
Mikrobiologia żywności
245
%a Wybrane zagadnienia z mikrobiologii żywności /
260
%a Warszawa :
%b Wydawnictwo SGGW,
%c 2010.
300
%a 120 s., [11] s. tabl. :
%b il. (w tym kolor.) ;%b il. (w tym kolor.) ;%b il. ;
%c 24 cm.
504
%a Bibliogr. przy rozdz.%a Bibliogr. przy rozdz.
504
%a Bibliogr. przy rozdz.
650
%a Mikrobiologia żywności
700
%a Błażejak, Stanisław
%e Redakcja
700
%a Gientka, Iwona
%e Redakcja